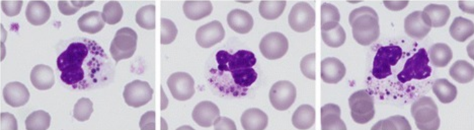
Flashcard 16 image

What unique antibodies in plasma do patients with the O blood type have? _____
Hint: name and isotype

Which class of cells have a round, densely stained nucleus with a small amount of cytoplasm? _____

Patients with the A blood type cannot receive which blood types? _____
Beta-thalassemia electrophoresis findings: No answer _____

What type of cell is represented in the image below? _____

Giant inclusions in polymorphonuclear neutrophils, which along with oculocutaneous albinism, and neutropenia is seen in _____ syndrome
What type of cell is represented in the image below? _____

Which of the following is a lymphoid / myeloid neoplasm with widespread involvement of bone marrow? _____

Which subtype of Hodgkin lymphoma is seen in the image below? _____

In -thalassemia major, 4 tetramers result in _____ erythropoiesis and extravascular hemolysis
Anemias: Classification and Approach
Flashcards
Hemolytic Anemias
Flashcards
Myeloproliferative Neoplasms
Flashcards
Myelodysplastic Syndromes
Flashcards
Acute Leukemias
Flashcards
Chronic Leukemias
Flashcards
Lymphomas and Lymphoid Neoplasms
Flashcards
Plasma Cell Disorders
Flashcards
Bleeding Disorders
Flashcards
Thrombotic Disorders
Flashcards
Get full access to all flashcards, spaced repetition, and progress tracking.
Start For Free